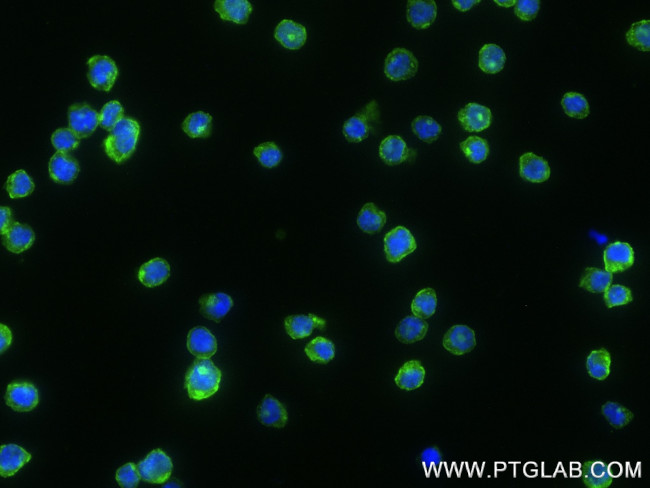
CD4 Antibody in Immunocytochemistry (ICC/IF)

Search
Proteintech
CD4 Recombinant Rabbit Monoclonal Antibody (240427E12)
{{$productOrderCtrl.translations['antibody.pdp.commerceCard.promotion.promotions']}}
{{$productOrderCtrl.translations['antibody.pdp.commerceCard.promotion.viewpromo']}}
{{$productOrderCtrl.translations['antibody.pdp.commerceCard.promotion.promocode']}}: {{promo.promoCode}} {{promo.promoTitle}} {{promo.promoDescription}}. {{$productOrderCtrl.translations['antibody.pdp.commerceCard.promotion.learnmore']}}



Please note: We are reviewing Western blot images included in the antibody testing data in our catalog, including those provided by third parties. Unless expressly labeled or annotated as “raw-unedited”, Western blot images included in the antibody testing data in our catalog may have been edited, optimized or otherwise adjusted for presentation.
产品信息
83513-7-RR
种属反应
宿主/亚型
Expression System
分类
类型
克隆号
抗原
偶联物
形式
浓度
规格
纯化类型
保存液
内含物
保存条件
运输条件
靶标信息
The CD4 antigen is involved in the recognition of MHC class II molecules and is a co-receptor for HIV. CD4 is primarily expressed in a subset of T-lymphocytes, also referred to as T helper cells, but may also be expressed by other cells in the immune system, such as monocytes, macrophages, and dendritic cells. At the tissue level, CD4 expression may be detected in thymus, lymph nodes, tonsils, and spleen, and also in specific regions of the brain, gut, and other non-lymphoid tissues. CD4 functions to initiate or augment the early phase of T-cell activation through its association with the T-cell receptor complex and protein tyrosine kinase, Lck. It may also function as an important mediator of direct neuronal damage in infectious and immune-mediated diseases of the central nervous system. Multiple alternatively spliced transcripts have been identified in this gene [RefSeq, July 2017].
仅用于科研。不用于诊断过程。未经明确授权不得转售。
篇参考文献 (0)
生物信息学
蛋白别名: CD4; CD4 antigen p55; cd4a; fCD4; Leu-3; T-cell surface antigen T4/Leu-3; T-cell surface glycoprotein CD4
基因别名: CD4
Entrez Gene ID: (Human) 920